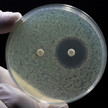
Antibiotika: Mehr Resistenzen bei geringerer Produktion

Thema: Engpass
Artikel zum Thema
„Sind sehr routiniert bei Suche nach Alternativen“ Mycare fürchtet Engpässe im Winter
Mit Sorge blicken Ärzt:innen und Apothekenteams in den bevorstehenden Herbst und Winter und warnen vor möglichen Lieferengpässen bei hunderten Arzneimitteln.... Mehr»
„Errungenschaften moderner Medizin“ stehen auf dem Spiel Antibiotika: Mehr Resistenzen bei geringerer Produktion
Jährlich sterben in der EU Zehntausende Menschen an Infektionen durch antibiotikaresistente Erreger, während der Nachschub mit neuen Antibiotika stockt.... Mehr»
Technische Anlage 7 Ab November: Neue Regeln für das E-Rezept
Für das E-Rezept gelten neue Vorgaben für die Abrechnung von Teilmengen, die Abgabe von Arzneimitteln der Dringlichkeitsliste und die erweiterten Abgaberegeln... Mehr»
Lieferengpässe und ethische Verantwortung Apotheker warnt: Arzneimittel-Triage stellt reales Risiko dar
Die Herausforderungen für Apotheker haben in den letzten Jahren zugenommen und werfen nicht nur organisatorische, sondern auch ethische Fragen auf. Auch... Mehr»
BfArM-Sondersitzung Dringlichkeitsliste: Versorgung grundsätzlich sichergestellt
Erst in der vergangenen Woche hatten die Vorstände der Kassenärztlichen Bundesvereinigung, Dr. Andreas Gassen, Dr. Stephan Hofmeister und Dr. Sibylle Steiner,... Mehr»
7,5-Meter-langes Bodentransparent Engpass-Aktion artet aus: „Es gab kein anderes Thema mehr“
Wer in den vergangenen Tagen die Rats-Apotheke im niedersächsischen Ebstorf besucht hat, kam nicht daran vorbei – einem 7,5-Meter-langem Bodentransparent, das... Mehr»
BfArM-Daten analysiert Lieferengpässe: Jeder dritte dauert länger als ein Jahr
Das Verwalten von Lieferengpässen kostet Apothekenteams wertvolle Zeit – etwa 20 bis 30 Stunden pro Woche, wie der Apothekenklimaindex der Abda zeigt. Eine... Mehr»
Austausch häufig unproblematisch Wissenschaftler: Engpass bedeutet nicht Versorgungslücke
In den vergangenen Wochen gab es medial wieder vermehrt Berichte zu Engpässen bei Arzneimitteln und steriler Kochsalzlösung. Zu beachten sei dabei, dass nicht... Mehr»
Rückkehr zu Pandemieregeln DAT: Mehr Handlungsfreiheit bei Engpässen
Lieferengpässe gehören laut Apothekenklimaindex für vier von fünf Apotheken zu den größten Ärgernissen im Versorgungsalltag. Apotheker:innen fordern seit Langem... Mehr»
VdK zu Lieferengpässen Sozialverband: Mehr Handlungsspielraum für Apotheken
Aufgrund der aktuell wieder medial präsenten Lieferengpässe schaltet sich nun auch der Sozialverband VdK ein. Das Bundesgesundheitsministerium (BMG) müsse nun... Mehr»
Medien zum Thema
- 1